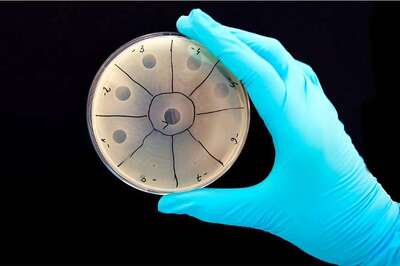
This Startup Wants to Fight Bacterial Infection With Viruses; You Wouldn’t Have Guessed it

Tech
Ireland Has An App That Alerts Users if They Have Been in Contact With Someone Who Has COVID
A number of countries are developing mobile-phone based technologies to help track the virus, prompting criticism from data privacy activists. The HSE said it was working with the Irish data protection agency to approve the app.
Amazon Wants Warehouse Workers to Shift to Groceries Unit, And Will Pay Them More
This move, known as labor sharing, highlights how the ecommerce giant is reallocating some of its vast workforce to handle a spike in online sales of groceries, as millions of American are stuck at home amid the COVID-19 outbreak.
Apple Releases COVID-19 Website and App With Screening Tool
The app will also answer frequently asked questions about the coronavirus disease with official information from the CDC.
COVID-19 Pandemic Leads to 40 Percent Increase in WhatsApp Usage
According to Kantar, in the later stages of the pandemic web browsing increases by 70 percent, followed by (traditional) TV viewing increasing by 63 percent and social media engagement increasing by 61 percent over normal usage rates.
Uber, Ola Drivers Left Without Income as Services Suspended Till At Least March 31
Drivers that News18 spoke to stated that Uber India has offered no financial assistance to those who aren’t infected, and Olacabs appears to be following suit.
Reliance Jio Announces Special Initiatives to Fight Against COVID-19 in India
Special JioFiber and Jio Mobile plans have been announced to facilitate customers during the ongoing COVID-19 pandemic.
This Startup Wants to Fight Bacterial Infection With Viruses; You Wouldn’t Have Guessed it
Felix, a biotech startup says that it wants to fight bacterial infections with viruses. This may just be a bad time to broach this idea, isn’t it? Drug resistant bacteria kills as many as 700000 people around the world every year and could kill more than...
Nokia 8.2, Nokia 5.3, Nokia 1.3 Launch Event: Here’s How to Watch the Live Stream
It is expected that HMD Global will launch at least three new Nokia devices which are going to include the company's first 5G enabled smartphones.
China's Baidu to Raise Staff Salaries Amid COVID-19 Virus Outbreak
Government efforts to stop the spread of COVID-19 in China have hit companies hard, causing them to cut salaries and lay off workers to fight declining demand.
3.5 Million eSIM-Capable Smartphones to Ship in India in 2020: Report
The shipments of eSIM phones quadrupled from a quarter of a million in 2018 to 1.5 million in 2019, with Apple contributing the most.
Xbox Series X to Feature Removable 1TB NVMe SSD, Custom AMD Zen 2 Octa-Core CPU
Microsoft is using Xbox Velocity Architecture, designed to improve the integration between hardware and software for streaming of in-game assets.
Redmi Note 9 Pro First Sale Begins Today: Price, Specifications, Offers and More
Follow up to the Redmi Note 8 Pro, the new smartphone comes with an improved camera setup, bigger battery and a slightly refreshed design.
Realme 6i to Officially Launch Today: Here’s What We Know So Far
The new Realme 6i will be launched at an online event in Myanmar and should be placed right below the Realme 6.
France Fines Apple $1.2 Billion For Pricing Deals With Resellers of iPad And Other Products
Two “premium” French Apple re-sellers, Tech Data and Ingram Micro, were also fined a total of 139 million euros ($155 million). Apple defended its operations in a statement saying its “investment and innovation supports over 240,000 jobs across the countr...
Coronavirus: Google Announces Multiple Steps, $50mn Fund in Fight Against Covid-19
Google CEO Sundar Pichai wrote steps taken in Search, YouTube results and ads, free work and learning tools and funds to fight against coronavirus.
Nike, Under Armour and Lululemon Closing Retail Stores Globally Due to Coronavirus
The three retail chains are majorly closing stores in North America and Western Europe among other regions to prevent the spread of Covid-19.